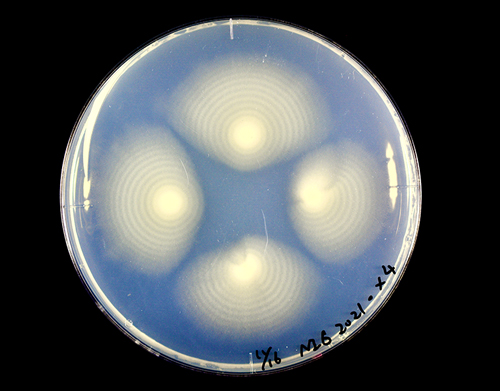
生命を形作る分子・細胞

国立遺伝学研究所では、桜の季節にあわせて構内を一般の皆様に開放し、日頃の研究成果を公開いたします。昨年までは新型コロナウイルスの流行に伴い『国立遺伝学研究所一般公開』を中止いたしましたが、今年は4年ぶりに開催いたします。ただし、コロナ禍は依然として終息していないため、例年より規模を縮小しての開催となること、ご理解よろしくお願いいたします。また、感染状況等により変更・中止する場合は、当ウェブサイト上でアナウンスします。
遺伝研研究者による日頃の研究成果の一端と、構内に咲く様々な種類の桜を楽しんでいただければと思います。
NEWS
ABOUT
- 日 時
- 2023年04月08日(土)9:00-16:00
- 会 場
- 国立遺伝学研究所
- 参加費
- 無料
- 内 容
- 桜の散策、パネル展示による研究紹介
- 駐車場
- 無し
※遺伝研構内や近隣にご来場者用の駐車場はございません。三島駅北口からのシャトルバス(無料)にご乗車いただくか、公共交通機関をご利用ください。
RESEARCH ACTIVITY
遺伝研は、遺伝情報を切り口に生命の謎に挑戦しています。当日は、私たちが日々取り組んでいる研究内容をパネル展示で紹介します。展示場所は複数ありますので、展示場所までのルートは当日配布のリーフレットでご確認ください。
展示①
生命を形づくる分子・細胞
(展示会場:講堂)
タンパク質、DNA、そして細胞の不思議に迫ります
展示②

研究を支える生き物たち
(展示会場:講堂)
多くの研究現場で活躍するモデル生物を紹介します
展示③

脳の発達と疾患
(展示会場:講堂)
神経回路を形づくる仕組みとその異常を紹介します
展示④

遺伝研の野生イネ
(展示会場:研究実験V棟)
世界に分布するイネの仲間を紹介します
展示⑤

ゲノムで迫る動物の多様性の不思議
(展示会場:講堂)
野外の動物に注目した進化の研究を紹介します
展示⑥

ゲノム情報が語る生命の進化
(展示会場:研究実験W棟)
遺伝情報と生物進化の研究を紹介します
MESSAGES FROM NIG
| ● | マスクの着用など、感染対策にご協力ください。 |
| ● | イベント当日に少しでも体調に異変を感じたら、自宅待機をお願いします。 ご来場はご遠慮ください。 |
| ● | 構内でのお食事はご遠慮ください。お弁当などの販売はしていません。 |
| ● | ゴミは各自でお持ち帰りください。 |
| ● | 動きやすい靴や服装でお越しください。 |
| ● | 研究施設のため、ペットを連れてのご来場はご遠慮ください。 |
| ● | 当日は三島駅北口から直行のシャトルバス(無料)を運行します。 |
| ● | 遺伝研構内や近隣にご来場者用の駐車場はありません。車・バイクでお越しの方は、三島駅周辺などの駐車場をご利用の上、シャトルバスにご乗車ください。 |
| ● | 自転車は総合案内所付近へ駐めてご見学ください。 |
| ● | 見学ルートには一部通りにくい所があります。車椅子等をご使用の方は職員がお手伝いしますのでご相談ください。 |
| ● | 展示品等には手を触れないようにお願いします。 |
| ● | 急病人が発生した場合や落し物を発見した際は、総合案内所またはお近くの職員にお申し付けください。 |
| ● | 当日の様子は記録のために写真撮影を行います。撮影した画像は、広報活動の一環としてウェブサイトや広報誌に掲載する場合があります。あらかじめご了承ください。 |
| ● | 感染状況により変更イベントの内容・スケジュール等が変更・中止になる可能性があります。中止の際にはご覧の一般公開HPでお知らせします。 |
| ● | 勧誘・迷惑行為を固く禁じます。 |
SAKURA CHANNEL
「さくらチャンネル」では、遺伝坂のふもとから遺伝研構内にかけて撮影した「桜の旅」などの動画や、桜にまつわる「やってみた動画」などを公開しています。「みてみて遺伝研!」は気軽にどこからでも、遺伝研の研究や桜に触れて楽しんでもらうことを目的とした特設サイトとなっています。
所要時間約5分40秒
OFFICIAL SNS
遺伝研の公式アカウントです。SNSで最新情報を発信しています。 遺伝研ちょっとだけ公開のハッシュタグは「#遺伝研ちょっとだけ公開」です。 皆様のご意見・ご感想をお聞かせください!





